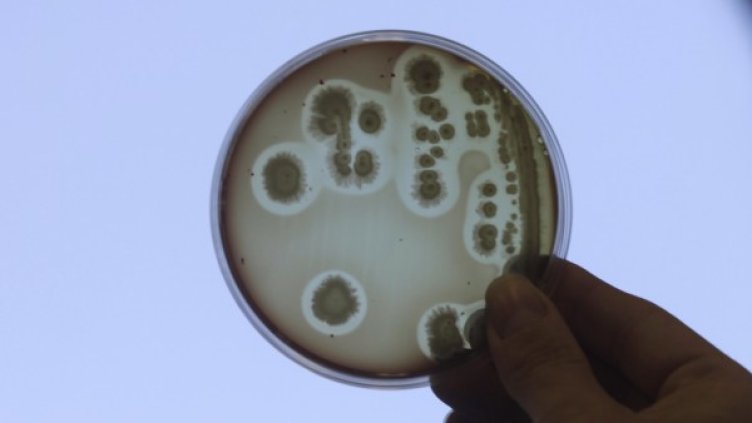
Снимка: Reuters, архив

3-годишно момиченце е починало от грип в Университетската болница на Стара Загора, потвърдиха за "24 часа" от болницата.
Смъртта е настъпила на 24 януари вечерта, но днес официално стана ясна причината за нея. От Националната референтна лаборатория в София са съобщили, че от изпратения им за изследване материал са изолирали грипен вирус щам "Виктория".
Детето е от съседното село Богомилово, расло е в добро семейство. До момента не било боледувало сериозно, редовно е имунизирано, нямало хронични заболявания и алергии към медикаменти.
Един ден в дома си детето внезапно вдигнало температура - 39,4 градуса, имало и кашлица. Вечерта на 20 януари към 22:30 часа посиняло и погледът му се вторачил, появила се симптоматика на гърч на крайниците, твърдят лекари.
Прието е в спешно отделение, оттам в детска клиника, където състоянието му се влошило и постъпило в реанимация. Лекувано е по всички възможни правила, включително с тамифлу, настояват от болницата, но въпреки това краят му е фатален.
В момента в област Стара Загора от остри респираторни заболявания страдат 248 на 10 000 души, по данни на РЗИ. Преди седмица заболяемостта бе по-висока - 306 на 10 000 човека и областта бе в предепидемиологична обстановка.
За да бъде обявена епидеция от грип, по закон болните трябва да стигнат 333 човека на 10 000.

Александър Каролев: Приключи епохата на евтиния дълг
Александър Каролев: Приключи епохата на евтиния дълг  Zara отново залага на Bad Bunny в стремежа да разшири влиянието си
Zara отново залага на Bad Bunny в стремежа да разшири влиянието си  УниКредит Булбанк е отличена от Euromoney като „Най-добра банка за частно банкиране в България“ за 2026 г.
УниКредит Булбанк е отличена от Euromoney като „Най-добра банка за частно банкиране в България“ за 2026 г.  Рен от ЕЦБ все още вижда малко признаци за трайно установяване на бързата инфлация
Рен от ЕЦБ все още вижда малко признаци за трайно установяване на бързата инфлация  Британският частен сектор се свива на фона на войната в Иран и кризата около премиера
Британският частен сектор се свива на фона на войната в Иран и кризата около премиера  Земеделският министър похвали директора на БАБХ и го смени
Земеделският министър похвали директора на БАБХ и го смени 
 Хлебарки XXXL в центъра на София, срещу СДВР и други институции
Хлебарки XXXL в центъра на София, срещу СДВР и други институции  В "България сутрин" на 22 май от 09:30 часа: Новите наредби за психотерапията у нас
В "България сутрин" на 22 май от 09:30 часа: Новите наредби за психотерапията у нас  Културна треска: Десетки се стекоха за евтини билети пред Народния театър (ВИДЕО)
Културна треска: Десетки се стекоха за евтини билети пред Народния театър (ВИДЕО)  Марио Манев пред Bulgaria ON AIR с разкрития за хаоса в Агенцията по вписванията
Марио Манев пред Bulgaria ON AIR с разкрития за хаоса в Агенцията по вписванията  Пожар в столично заведение помрачи шампионските празненства на ЦСКА
Пожар в столично заведение помрачи шампионските празненства на ЦСКА  Двама души загинаха при наводнения в Турция
Двама души загинаха при наводнения в Турция 
 Чест и привилегия е да бъдеш капитан на ЦСКА
Чест и привилегия е да бъдеш капитан на ЦСКА  Бивш на ЦСКА прави фурор в Румъния
Бивш на ЦСКА прави фурор в Румъния  Любо Пенев с емоционално съобщение
Любо Пенев с емоционално съобщение  БФС наказа тежко ЦСКА
БФС наказа тежко ЦСКА  Барса реши за Маркъс Рашфорд
Барса реши за Маркъс Рашфорд  Лудогорец с важна новина за ЦСКА
Лудогорец с важна новина за ЦСКА 
 3 зодии с финансов успех в седмицата 25 – 31 май 2026
3 зодии с финансов успех в седмицата 25 – 31 май 2026  11 правила за дълъг живот от Петър Дънов
11 правила за дълъг живот от Петър Дънов  Тест: Какво послание има за вас Вселената
Тест: Какво послание има за вас Вселената  10 празнични десерта за 21 май
10 празнични десерта за 21 май  3 зодии с огромен късмет в сезона на Близнаци
3 зодии с огромен късмет в сезона на Близнаци  5 семена, които нутриционистите препоръчват – помагат за хормонален баланс
5 семена, които нутриционистите препоръчват – помагат за хормонален баланс 
 продава, Парцел, 5000 m2 Варна област, с.Кичево, 42900 EUR
продава, Парцел, 5000 m2 Варна област, с.Кичево, 42900 EUR  продава, Парцел, 1800 m2 Пловдив област, гр.Баня, 19000 EUR
продава, Парцел, 1800 m2 Пловдив област, гр.Баня, 19000 EUR  продава, Парцел, 1128 m2 София област, с.Желен, 11000 EUR
продава, Парцел, 1128 m2 София област, с.Желен, 11000 EUR  продава, Парцел, 15000 m2 София област, с.Хераково, 375000 EUR
продава, Парцел, 15000 m2 София област, с.Хераково, 375000 EUR  продава, Парцел, 3800 m2 София област, с.Хераково, 95000 EUR
продава, Парцел, 3800 m2 София област, с.Хераково, 95000 EUR  продава, Парцел, 8380 m2 Бургас област, с.Равда, 69000 EUR
продава, Парцел, 8380 m2 Бургас област, с.Равда, 69000 EUR 
 Пуснаха под гаранция бизнесменът, предложил подкуп на областния управител на Добрич
Пуснаха под гаранция бизнесменът, предложил подкуп на областния управител на Добрич  25 изявени личности и творчески колективи са новите носители на награда „Варна” (СНИМКИ)
25 изявени личности и творчески колективи са новите носители на награда „Варна” (СНИМКИ)  Нойер се завръща в Бундестима
Нойер се завръща в Бундестима  Съдът реши: Глоба за Пепи Еврото и вече не го издирват
Съдът реши: Глоба за Пепи Еврото и вече не го издирват  Модернизират ВиК инфраструктурата по Северното Черноморие
Модернизират ВиК инфраструктурата по Северното Черноморие  Радев развъртя метлата: Смениха и шефовете на БЕХ
Радев развъртя метлата: Смениха и шефовете на БЕХ 
 SpaceX е готова за Уолстрийт: Състоянието на Мъск може да скочи до 1 трилион долара
SpaceX е готова за Уолстрийт: Състоянието на Мъск може да скочи до 1 трилион долара  Откриха огромни залежи на литий в Апалачите: Стигат за 500 млрд. смартфона
Откриха огромни залежи на литий в Апалачите: Стигат за 500 млрд. смартфона  Из разсекретените документи в САЩ: 13 изтребителя са преследвали едно НЛО
Из разсекретените документи в САЩ: 13 изтребителя са преследвали едно НЛО  Psyche получи гравитационен тласък от Марс: Увеличи скоростта си с 1600 км/ч (снимки)
Psyche получи гравитационен тласък от Марс: Увеличи скоростта си с 1600 км/ч (снимки)  Луната, звездният куп „Ясли“ и трио планети красят небето на 21 май
Луната, звездният куп „Ясли“ и трио планети красят небето на 21 май  Гледайте на живо: SpaceX изстрелва новата си мегаракета Starship V3 на 21 май
Гледайте на живо: SpaceX изстрелва новата си мегаракета Starship V3 на 21 май 












